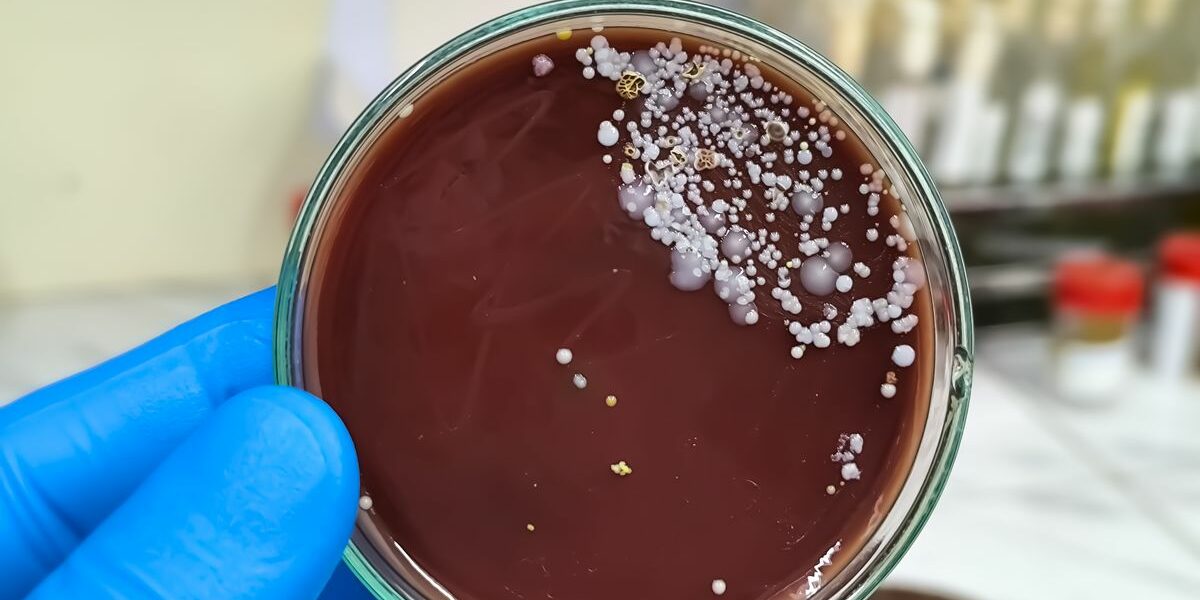
0_GettyImages-2191922528.jpg

This post was originally published on here
Scientists have warned the Candida auris is a ‘significant medical concern’
A dangerous, drug-resistant fungus is spreading worldwide and evolving traits that make it harder to treat, according to scientists. Candida auris, an invasive yeast that primarily affects people with weakened immune systems, has now been detected in more than 60 countries across six continents.
Researchers warn the pathogen is becoming increasingly virulent and poses a growing threat to global health. Fungal infections already affect an estimated 6.5 million people each year and are linked to death rates of more than 50 per cent, even when antifungal treatment is available.
C. auris is of particular concern because it spreads easily in healthcare settings and is often resistant to multiple antifungal drugs. A new scientific review highlights several biological features that help the fungus survive and spread. These include its ability to shift from a yeast-like form into different structure that aids invasion and drug resistance, as well as specialised proteins that allow it to cling tightly to human skin.
“Skin colonisation by C auris is a significant medical concern because colonised patients may facilitate inter- and intra-hospital transmission of C auris to other patients,” the researchers write in the study.
The review also warns that infections are frequently misdiagnosed, delaying effective treatment. “The diagnosis of C auris infections is often hampered by misidentification, leading to delays in starting appropriate antifungal therapy,” the study explains. “Taken together, these data underscore the need to develop novel antifungal agents with broad-spectrum activity against human fungal pathogens, to improve diagnostic tests, and to develop immune- and vaccine-based adjunct modalities for the treatment of high-risk patients.”
Because the fungus can survive on surfaces and medical equipment, outbreaks are often linked to devices such as catheters, feeding tubes and ventilators. The World Health Organisation (WHO) classified C. auris as a ‘critical priority’ pathogen in 2022 due to its rapid spread and increasing resistance to existing treatments.
In England, confirmed cases remain relatively rare but are rising. UK Health Security Agency (UKHSA) data show 637 cases were reported between January 2013 and December 2024, with annual numbers increasing steadily since 2020. There were 26 cases in 2021, 38 in 2022, 93 in 2023 and 178 in 2024.
Dr Rohini Manuel, Consultant Microbiologist at UKHSA, said earlier this year: “Rates of C auris in hospitals in England are very low, however they have been rising in recent years. The data covers infections and colonisations, which means that the fungus is present on the skin but is not causing illness.
“UKHSA is working with the NHS to investigate the reasons behind the increase, although factors may include a rise in the fungus globally. Hospital outbreaks in this country are rare but we are supporting a small number of Trusts in managing ongoing outbreaks of colonised patients, coordinating infection prevention and control efforts, and maintaining patient safety.”
The agency says C. auris was first identified in 2009 and has since spread rapidly worldwide, particularly following the lifting of COVID-19 travel restrictions. It can cause serious infections of the bloodstream, wounds and ears, and is carried on the skin and in bodily fluids. Some people may carry the fungus without showing symptoms.
“C. auris, previously rarely detected in England, has been emerging over the last decade, particularly following the lifting of travel restrictions imposed during the COVID-19 pandemic period,” the UKHSA said.
Symptoms often resemble bacterial infections, including fever and chills, but vary depending on where the infection develops. Outside the UK, severe invasive infections are associated with ‘high mortality’, the UKHSA warns.
Scientists say the threat from fungal diseases may worsen with climate change. Separate research from scientists at the University of Manchester published earlier this year found that rising global temperatures could accelerate the spread of fungal pathogens, including Aspergillus fumigatus, which causes millions of infections and up to 2.5 million deaths worldwide each year.
The study’s lead author said C. auris is believed to be the first fungal pathogen that emerged due to climate change.
The latest review was published in the journal Nature Microbiology.